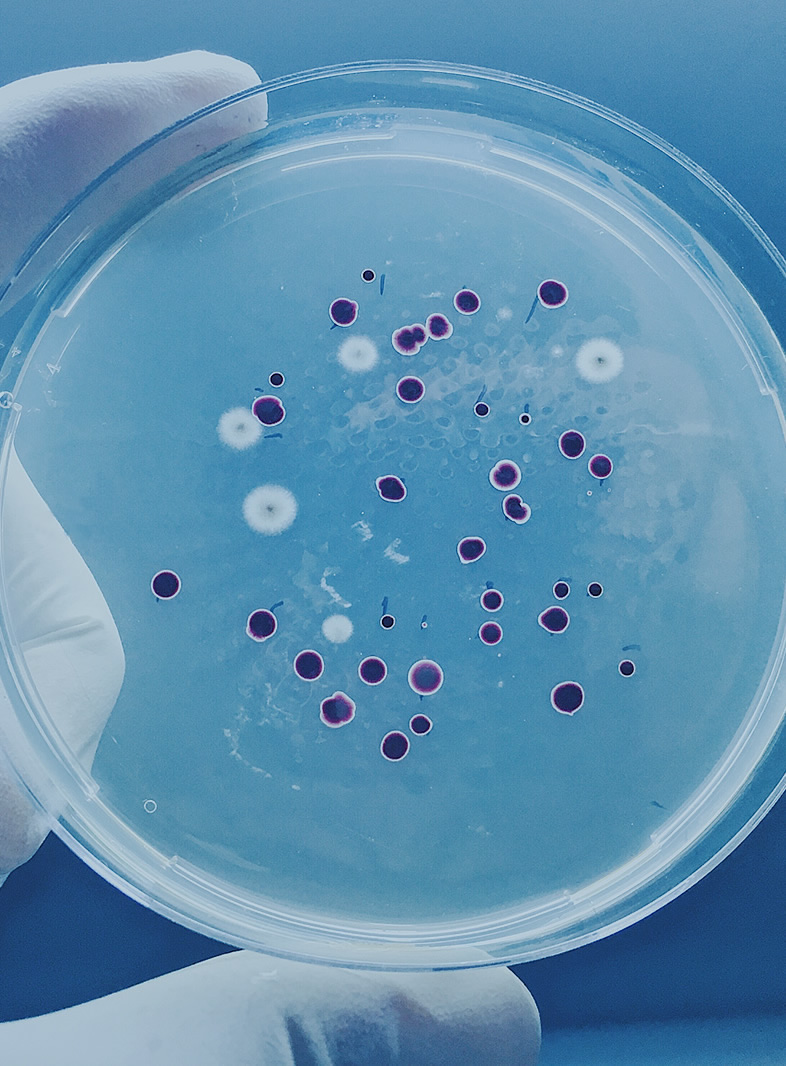

経営者のための、最初の相談窓口
山田の窓口は、経営課題から人脈づくり、営業、財務、会食の場づくり、さらにはプライベートなお悩みまで、
経営者の目の前の課題に寄り添う完全紹介制の相談窓口です。
代表山田自身の経験と信頼関係を土台に、必要に応じて厳選した専門家とも連携しながら、単なる紹介で終わらず解決まで伴走します。
役員・幹部のように近く、外部コンサルのように専門的で、家族や友人のように話せる存在を目指しています。
SERVICE
事業案内
山田の窓口は、経営者向けの相談窓口を軸に、営業・戦略支援、そして会員制割烹を活用した信頼ある出会いの場づくりまでを一体で提供する事業です。課題の相談から具体的な支援、人脈形成までを切り離さず、経営者に寄り添いながら実務と関係性の両面を支えることを強みとしています。
-
経営者向け相談
consulting
経営課題から日々の判断、時にはプライベートなお悩みまで、経営者がまず最初に相談できる窓口です。
代表の山田が直接話を受け止め、必要に応じて厳選した専門家とも連携しながら、単なる紹介で終わらず、解決まで伴走する支援を行います。
-
営業戦略・事業成長支援
support
見込み客の紹介、営業代行、営業戦略の企画、社員育成、財務分析や戦略立案まで、事業成長に必要な支援を幅広く提供します。経営者との強い関係性とネットワークを生かし、売上拡大や販路開拓、事業の前進につながる実務支援を行う領域です。
-
経営者コミュニティ運営
community
完全会員制・住所非公開の「麻布やま屋」を拠点に、経営者同士が安心して集い、信頼関係を深められる場を提供しています。会食や交流会を通じて人と人をつなぎ、新たなご縁や協業のきっかけを生み出す、山田の窓口ならではの価値を担う事業です。

経営者に深く寄り添い、信頼で価値を届ける仕事に挑戦したい方へ。
山田の窓口の考えや活動を発信しています。











